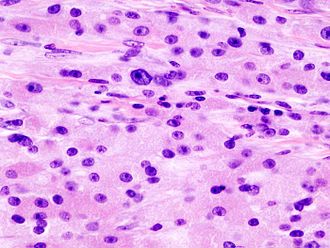

Projects

Ajitsuke Tamago
Thermal modeling to find the perfect Ramen egg

Lego database
Building a Lego database based on Rebrickable...

Lego brick investigation
Exploring Lego bricks since 1949...

Global Health Observatory
Demonstrating access and plotting of the WHO's GHO database

Simulating Chaos
Model of a multiple pendulum system
Works in progress

AI vs AI
Turret defense game pitting different machine learning against each other
Drug diffusion in tumours
Image analysis and mass transport modeling

Exploring sports trends
Machine learning exploration of the springboks

Controlling chaos
Control system for double pendulum

















